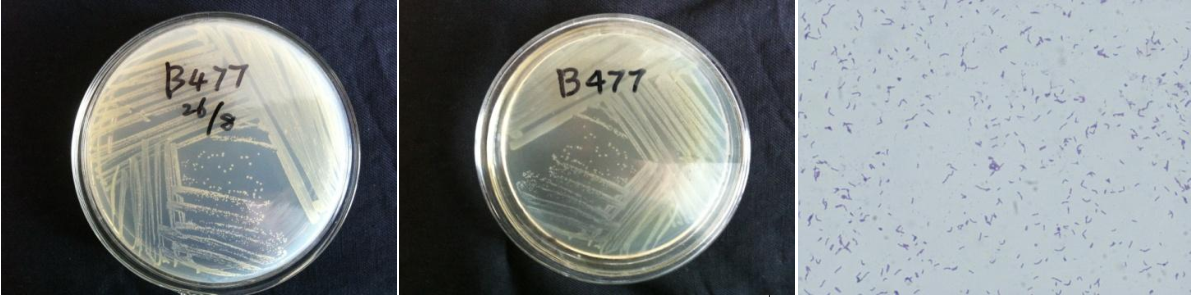

Loading...
| StrainNO | B477 |
| Classification | Bacillus |
| 16s rDNA sequence | ATCTGGTTCACCTTAGGCGGCTGGCTCCTTACGGTTACCCCACCTACTTCGGGTGTTACAAACTCTCGTGGTGTGACGGGCGGT GTGTACAAGGCCCGGGAACGTATTCACCGCGGCATGCTGATCCGCGATTACTAGCGATTCCAGCTTCATGCAGGCGAGTTGCAG CCTGCAATCCGAACTGAGAATGGTTTTATGGGATTCGCTTAACCTCGCGGTTTTGCAGCCCTTTGTACCATCCATTGTAGCACG TGTGTAGCCCAGGTCATAAGGGGCATGATGATTTGACGTCATCCCCACCTTCCTCCGGTTTGTCACCGGCAGTCACCTTAGAGT GCCCAACTGAATGCTGGCAACTAAGATCAAGGGTTGCGCTCGTTGCGGGACTTAACCCAACATCTCACGACACGAGCTGACGAC AACCATGCACCACCTGTCACTCTGTCCCCCGAAGGGGAACGCCCTATCTCTAGGGTTGTCAGAGGATGTCAAGACCTGGTAAGG TTCTTCGCGTTGCTTCGAATTAAACCACATGCTCCACCGCTTGTGCGGGCCCCCGTCAATTCCTTTGAGTTTCAGTCTTGCGAC CGTACTCCCCAGGCGGAGTGCTTAATGCGTTTGCTGCAGCACTAAAGGGCGGAAACCCTCTAACACTTAGCACTCATCGTTTAC GGCGTGGACTACCAGGGTATCTAATCCTGTTTGCTCCCCACGCTTTCGCGCCTCAGCGTCAGTTACAGACCAGAAAGCCGCCTT CGCCACTGGTGTTCCTCCACATCTCTACGCATTTCACCGCTACACGTGGAATTCCGCTTTCCTCTTCTGTACTCAAGTTCCCCA GTTTCCAATGACCCTCCCCGGTTGAGCCGGGGGCTTTCACATCAGACTTAAGGAACCGCCTGCGCGCGCTTTACGCCCAATAAT TCCGGACAACGCTTGCCACCTACGTATTACCGCGGCTGCTGGCACGTAGTTAGCCGTGGCTTTCTGGTTAGGTACCGTCAAGGT ACCGGCAGTTACTCCGGTACTTGTTCTTCCCTAACAACAGAACTTTACGACCCGAAAGCCTTCATCGTTCACGCGGCGTTGCTC CGTCAGACTTTCGTCCATTGCGGAAGATTCCCTACTGCTGCCTCCCGTAGGAGTCTGGGCCGTGTCTCAGTCCCAGTGTGGCCG ATCACCCTCTCAGGTCGGCTACGCATCGTCGCCTTGGTGAGCCATTACCTCACCAACTAGCTAATGCGCCGCGGGCCCATCTGT AAGTGATAGCTTGCGCCATCTTTCAGCTTTTCCTCATGAGAGGAAAAGGATTATCCGGTATTAGCTCCGGTTTCCCGAAGTTAT CCCAGTCTTACAGGCAGGTTGCCCACGTGTTACTCACCCGTCCGCCGCTAACCTTCAGGAGCAAGCTCCTGAAGATCGCTCGAC TGCATGTATAGACAGGCCGCCC |
| Strain Morphology Photos | |
| Morphological Description | round;light yellow;edge neatly;steamed bun shaped;slippy;sticky;Rod;having spore;terminal spore |